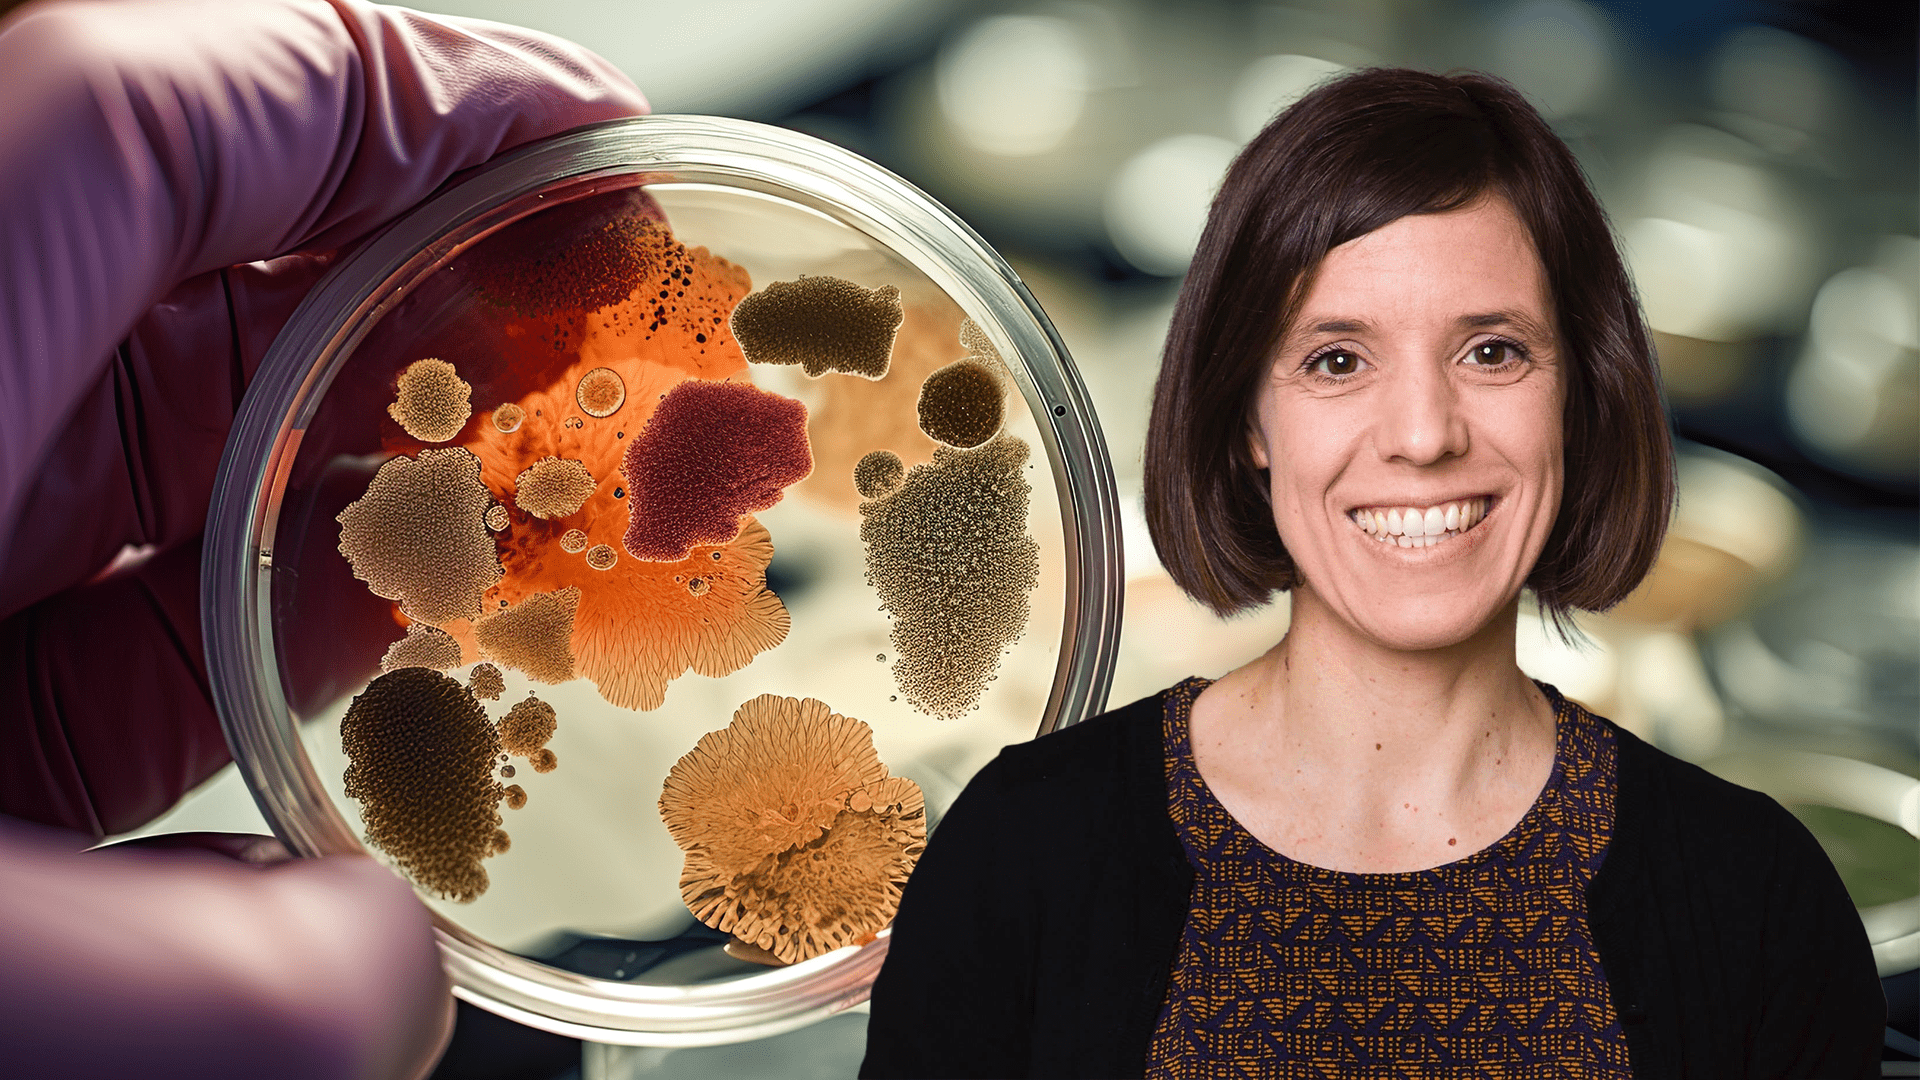

SciLifeLab fellow receives prestigious award
The Sven and Ebba-Christina Hagberg Foundation has proudly announced the recipients of their esteemed awards for the year 2023. SciLifeLab fellow and Stockholm University researcher Kristina Jonas, has been selected as the recipient of the foundation’s personal prize and research support, totaling 650,000 SEK.
Kristina Jonas received the award “for biochemical and molecular biological studies of bacterial growth and reproduction.”
The Sven and Ebba-Christina Hagberg Foundation is committed to advancing scientific research, with a primary focus on the medical and biochemical domains. Each year, the foundation recognizes and supports exceptional young researchers in Sweden, alternating between different categories. The selection process involves close collaboration with the Royal Swedish Academy of Sciences and Karolinska Institutet.
Sven Hagberg (1894-1961) was a graduate engineer and cereal chemist. He developed a new method for measuring the baking characteristics of flour. This method called the “Hagberg Falling Number”, is now in use the world over. Ebba-Christina Hagberg (1900-1972) was involved in organizational work and shared her husband’s interest in foreign cultures. The couple had no children of their own but bequeathed their property to the Foundation.
For additional information, please contact:
Dr. Anna Bodegård-Westling, Chairperson of the Foundation
anna.bodegard@anicura.se
Prof. Gunnar von Heijne, Board Member
gunnar.von.heijne@dbb.su.se